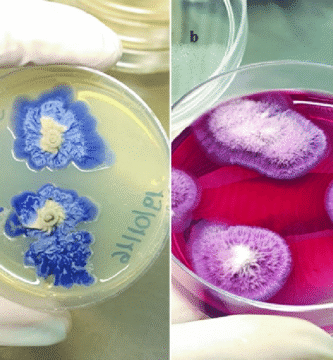

El uso histórico de los hongos en rituales y ceremonias

Hongos en la acuicultura y la piscicultura

Los hongos más venenosos del mundo

Hongos en la producción de fragancias naturales

Los hongos más antiguos conocidos por la humanidad

Hongos como indicadores de cambios climáticos